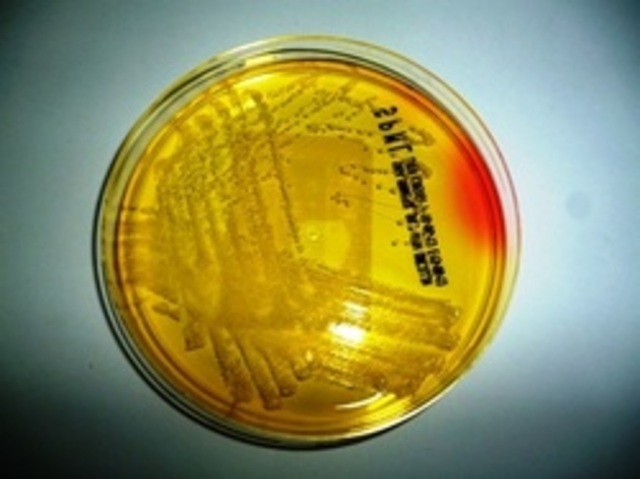
Discovery of MRSA

-
-
First hospital outbreak of MRSA in the US, at the Boston City Hospital, in Massachusetts.
-
-
2% of hospital-acquired S. aureus infections could be attributed to MRSA
-
-
A1990 study tested MRSA isolates obtained from veterans and found they could be killed by several substances, including bacitracin, nitrofurantoin, hydrogen peroxide, novobiocin, netilmicin and vancomycin. The study went on to conclude that netilmicin might be useful as an alternative to intravenous vancomycin, and suggested that topical applications of hydrogen peroxide may be useful to reduce MRSA on skin and some mucous membranes.
-
MRSA is associated with the deaths of 4 children"in Minnesota and North Dakota"
-
After a successful pilot scheme to tackle MRSA, the UK National Health Service announced its Clean Your Hands campaign. Wards were required to ensure that alcohol-based hand rubs are placed near all beds so that staff can hand wash more regularly. It is thought that even if this cuts infection by no more than 1%, the plan will pay for itself many times over."
-
"A" was a new type of surface cleaner, incorporating accelerated hydrogen peroxide, which was pronounced "a potential candidate" for use against the targeted microorganisms"
-
" A report in Nature identified a new antibiotic, called platensimycin, that had demonstrated successful use against MRSA."
-
The first incidence of MRSA in a pet" was recorded."
-
"Study found that 4.6% of patients in U.S. health care facilities were infected or colonized with MRSA"
-
" TheU.S. Food and Drug Administration (FDA) approved a rapid blood test (StaphSR assay) that can detect the presence of MRSA genetic material in a blood sample in as little as two hours. The test is also able to determine whether the genetic material is from MRSA or from less dangerous forms of Staph bacteria."
-
ISDA releases guidelines for the treatment of MRSA.
-
" Lawrence Tynes, Carl Nicks, and Johnthan Banks, all of the Tampa Bay Buccaneers were diagnosed with MRSA."
Want to make a timeline like this?
Use Timetoast to turn dates, events, milestones, and phases into a clear visual timeline you can build and share. Timetoast is a timeline maker for work, school, research, and stories.